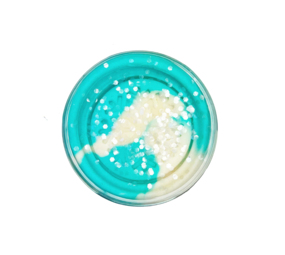
Dutch Dough Invitation to Imagine Klei Winter Ice

Knutselen
4 producten

Log in en voeg producten toe door op het icoon te klikken.
15% OP BIJNA ALLES VANAF €75 - CODE LAZYSUMMER15% OP BIJNA ALLES VANAF €75 - MET CODE LAZYSUMMER(actievoorwaarden)

Log in en voeg producten toe door op het icoon te klikken.
15% OP BIJNA ALLES VANAF €75 - CODE LAZYSUMMER15% OP BIJNA ALLES VANAF €75 - MET CODE LAZYSUMMER(actievoorwaarden)